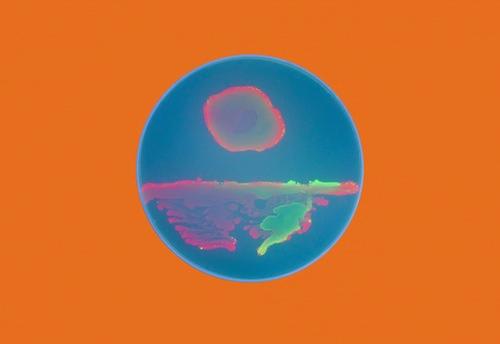

Open Air Salon: Lauren Berlant
Public Art Fund
Talk on
Public Art Fund

Tribeca / Downtown
City Hall Park
Broadway & Chambers Street
New York, NY 10007
Broadway & Chambers Street
New York, NY 10007

Danh Vo, We The People (detail), 2011-14. Copper. Collection François Odermatt, Montreal. Photo: James Ewing
Artist Talk with Liv Mette Larsen and Paula De Luccia
William Holman Gallery
Talk on
William Holman Gallery
East Village / Lower East Side
65 Ludlow Street
(Corner of Grand)
New York, NY 10002
(Corner of Grand)
New York, NY 10002
 Sculpture by Paula DeLuccia: Painting by Liv Mette Larsen
Sculpture by Paula DeLuccia: Painting by Liv Mette Larsen
Book Launch for Jean-Baptiste Bernadet's FUGUE
Regina Rex
Opening on
Regina Rex
East Village / Lower East Side
221 Madison Street
New York, NY 10002
New York, NY 10002
Weltstadt – Who Creates the City?
Goethe-Institut New York
On View
Goethe-Institut New York
East Village / Lower East Side
Goethe-Institut Wyoming Building
5 East 3rd Street
New York, NY 10003
5 East 3rd Street
New York, NY 10003

Conicon 2.0
Group Show
Curated by Josef Pinlac
Con Artist Collective & Gallery
Opening on
On View
Con Artist Collective & Gallery
East Village / Lower East Side
119 Ludlow Street
New York, NY 10002
New York, NY 10002
Performance: Rachel Garrard "Performance: Interrelated Echoes" curated by Mitra Khorasheh at Klemens Gasser & Tanja Grunert
Chinatown/LES: 33 Orchard street, 6-8pm
Chinatown/LES: 33 Orchard street, 6-8pm

Conversation | Artist Amie Siegel and Nicholas Cullinan On Provenance
Swiss Institute / CONTEMPORARY ART
Talk on
Swiss Institute / CONTEMPORARY ART
Soho
18 Wooster Street
New York, NY 10013
New York, NY 10013
Amie Siegel (American, b. 1974). Provenance (still), 2013. HD video, color, sound; 40 min., 30 sec. Courtesy the artist and Simon Preston Gallery, New York.
Artist Talk: Claire Sherman "Sempervirens" at DC Moore
22 street: 535 West 22nd st, 2, 6-8pm
22 street: 535 West 22nd st, 2, 6-8pm
Where Is the Art in Bio Art?
Yacov Avrahami
Curated by Suzanne Anker, Suzanne Anker, Brandon Ballengée, Shane Boddington, Vincent Chen, Anne Clinton, Thibaut Dapigny, Erin Davis, Lina Espinosa, Daniella Garcia-Rosales, Zachary La Rosa, Yi Yao Li, Lian Lian, Laura Murray, Alessia Resta, Tarah Rhoda, Henry G. Sanchez, Richard Walshe, Darya Warner
SVA Flatiron Gallery
Opening on
On View
SVA Flatiron Gallery
Flatiron / Gramercy
133/141 West 21st Street
New York, NY 10011
New York, NY 10011
Yacov Avrahami
ALI MEDINA, Amanda Church, Amy Friedberg, Anya Zelinska, Bundith Phunsombatlert, Daniel Vasquez, Esperanza Mayobre, Felix Plaza, Juana Valdes, Katherine Tzu-Lan Mann, Liz Zanis, Paul Shore, Theresa Bloise "Treasure Island" curated by Julie Chae at Lower East Side Printshop
37 street: 306 W 37 street, floor 6, 6-8pm
37 street: 306 W 37 street, floor 6, 6-8pm
Preview: Guy Dessapt, Louis Dali, Malva, Raymond Campbell "Impressions of Autumn" curated by Vicki Arnot at Arnot Gallery / Herbert Arnot, Inc.
57 street: 250 W 57 street, 10 fl, suite 1014, 10am-3:30pm
57 street: 250 W 57 street, 10 fl, suite 1014, 10am-3:30pm

Treasure Island
Theresa Bloise, Amanda Church, Amy Friedberg, Esperanza Mayobre, Ali Medina, Bundith Phunsombatlert, Felix Plaza, Paul Shore, Katherine Tzu-Lan Mann, Juana Valdes, Daniel Vasquez, Liz Zanis, and Anya
Curated by Julie Chae
Lower East Side Printshop
Opening on
On View
L
Ali Medina, Untitled #2, Monoprint, 2014
Lower East Side Printshop
Hell's Kitchen
306 West 37th Street
6th Floor
New York, NY 10018
6th Floor
New York, NY 10018
Lecture: Photography: Cheney Orr "A Future Uncertain: Young in Ukraine" atUkrainian Institute of America
79 street: 2 E 79 street, 6-8pm
79 street: 2 E 79 street, 6-8pm
Bond New York 25 Hudson St Soheyla Ben-Amotz Expressions of Gratitude 6:30-8:30
Center for Book Arts at Lilac Museum Steamship Hudson River Park's Pier 25 at West Street and N. Moore St Roundtable Discussion The Artist Book as Manifesto 5:30 free
Flair 88 Grand St George Sellers The Arete Collection RSVP@
Gasser & Grunert 33 Orchard St performance: Rachel Garrard Interrelated Echoes 6-8
Battle of the Artist Bands
SHOW ROOM | Gowanus
Performance on
SHOW ROOM | Gowanus
Gowanus
460 Union Street
Brooklyn, NY 11231
Brooklyn, NY 11231

The Wooster Group’s White Homeland Commando
Spectacle
Screening on
Spectacle
Williamsburg
124 South 3rd Street
Brooklyn, NY 11211
Brooklyn, NY 11211
Additional Screenings:
Wednesday October 08, 2014 10:00 PM
Monday October 13, 2014 10:00 PM
Voyage to Europe – From Life to Death to Life
 A screening of Serbian video art
A screening of Serbian video art
Curated by Zorana Djakovic Minitti and Mia David
Residency Unlimited
Screening on
Residency Unlimited
Carroll Gardens
360 Court Street
Unit #4
New York, NY 11231
Unit #4
New York, NY 11231
Ana Nedeljković & Nikola Majdak Jr, Rabbitland, 2013, video still
DAY IN, DAY
OUT: Art as Social Engagement
With Nicolás Dumit Estévez, Guerrilla Girls, Alicia Grullón, Juan Sánchez, and Mary Ting
El Museo del Barrio
Talk on
El Museo del Barrio
Harlem
1230 Fifth Avenue
New York, NY 10029
New York, NY 10029
|
|



No comments:
Post a Comment